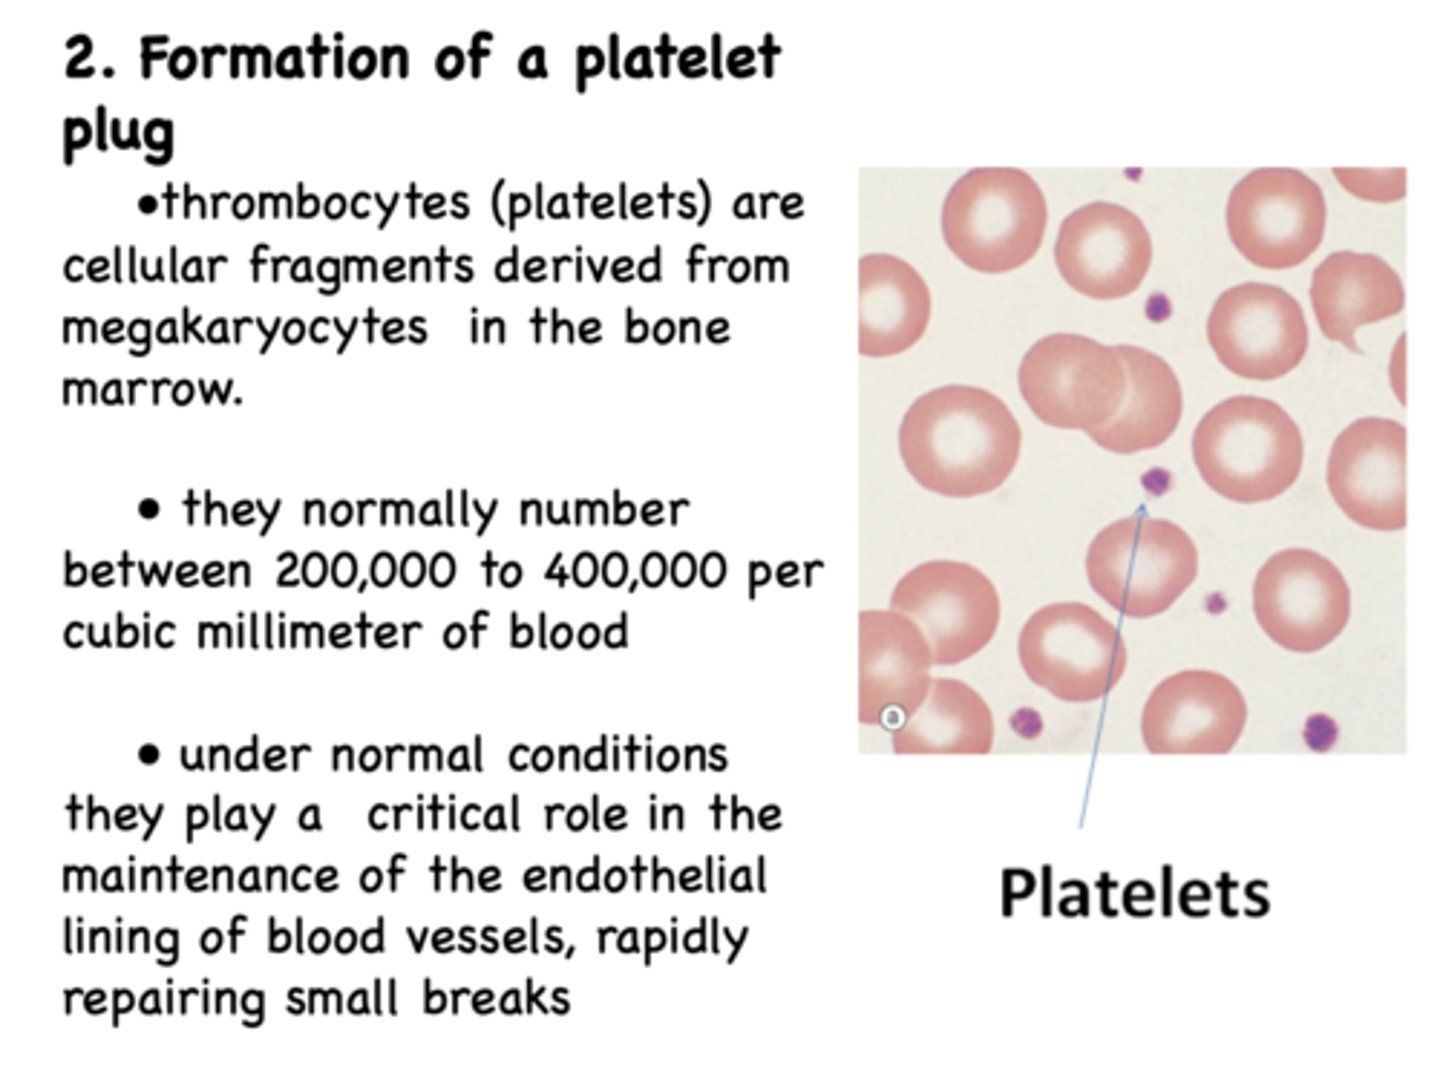
<p>megakaryocytes</p>

Cardio/Renal 21 - Hemostasis (Dr. Leavis)
1/89
There's no tags or description
Looks like no tags are added yet.
Name | Mastery | Learn | Test | Matching | Spaced | Call with Kai |
|---|
No analytics yet
Send a link to your students to track their progress
90 Terms
Hemostasis encompasses maintenance of _____________, prevention of _____________ in the event of an injury to a vessel
blood flow, blood loss

when a blood vessel ruptures, what is the 1st step in hemostasis?
vascular spasm/ vasoconstriction

when a blood vessel ruptures, what is the 2nd step in hemostasis?
formation of platelet plug

when a blood vessel ruptures, what is the 3rd step in hemostasis?
blood coagulates to form a clot

when a blood vessel ruptures, what is the 4th step in hemostasis?
growth of fibrous tissue into the clot to close the rupture permanently

Immediate reflex response to loss of pressure at injury site causes...
contraction of vascular smooth muscle and constriction

Contraction of vascular smooth muscle and constriction leads to ________ and retraction of the damaged area into surrounding tissue to protect exposure to ___________
decrease blood loss; foreign materials

What causes vascular spasm: vasoconstrction?
What causes vascular spasm: vasoconstrction?
- Local myogenic spasm
- Sympathetic nervous system
- Local chemical factors released from damaged tissue and platelets (thromboxane S2, kinins, and serotonin)
- Blood loss into a tissue can increase local tissue pressure (turgor), slowing blood loss

_____________ play a critical role in the maintenance of the endothelial lining of blood vessels, rapidly repairing small breaks
thrombocytes (platelets)

With vessel injury, platelets quickly form a temporary ___________ in the vessel wall to stem the flow of blood until a more permanent repair can be made.
Platelet plug

Where are thrombocytes (platelets) derived from?
megakaryocytes
what part of the exposed connective tissue in a vessel rupture is positively charged and attracts platelets to the cut?
collagen

What amino acids in collagen makes it positively charged and allows it to attract platelets to exposed breaks in the wall?
lysine, hydroxylysine

the adhesion of platelets to exposed collagen is dependent upon 2 things:
GPIb/IX/V (glycoprotein complex) & von Willibrand Factor (vWF)

Platelet plug formation occurs in several steps
adhesion, activation, aggregation

von Willibrand Factor binds to a site on the ____ subunit of the GpIb/IX/V and also to exposed collagen fibers
Ib

the GpIb/IX/V component of platelet adhesion is located on the ___________
platelet surface

What are two vasoconstrictors released by platelets during aggregation that decrease blood flow?
- Thromboxane A2
- Serotonin

von Willibrand Factor is secreted by ________
endothelial cells and platelets

During activation of platelets, they also release ______ which causes additional platelets to attach to the site
ADP

an increase in ADP causes a _________ in platelet aggregation
increase

Adhesion of platelets induces their activation which results in... (2)
morphological changes & release of thomboxane A2/serotonin/ADP

disorder where platelets fail to adhere to epithelial tissue:
Von Willebrand Disease

what glycoprotein complex allows platelets to adhere to the vascular epithelium?
GpIb/IX/V

During platelet activation and aggregation, secretion of other substances by platelets including growth factors, platelet factors (PF3) are needed for...
Plasma coagulation, calcium, kinins, etc.

what protein aids and reacts with GpIIb/IIIa to crosslink platelets together and form a plug?
fibrinogen

Undamaged endothelial cells adjacent to the injury site secrete two potent inhibitors of platelet adhesion, activation and aggregation:
- Prostacyclin
- Nitric oxide (NO)

How do we limit the platelet response to the site of injury?
Prostacyclin and nitric oxide (NO) are two potent inhibitors of platelet adhesion

______________ is defined as the formation of the platelet plug
primary hemostasis

t/f: platelets contain actin and myosin in amounts comparable to skeletal muscle
true

what glycoprotein complex allows platelets to adhere to each other during aggregation?
GpIIb/IIIa

t/f: with small injuries, the platelet plug alone can't stop blood loss
false, platelet plug alone CAN stop blood loss

How quick does blood coagulation occur in a severe injury?
15-20 seconds

How quick does blood coagulation occur in a minor injury?
1-2 minutes

When is blood coagulation triggered?
When blood comes into contact with collagen from a damaged vessel or other fluids resulting from tissue trauma

initiation of coagulation occurs by formation of:
prothrombin activator complex

lack of platelets can leads to formation of multiple small hemorrhages under the skin called ____________
petechiae

activation of _________ is the step that both intrinsic and extrinsic pathways share
prothrombin

in which coagulation pathway does coagulation begins within the bloodstream?
intrinsic pathway

Which coagulation pathway begins with trauma to the tissues outside the vessel?
extrinsic pathway

What factor is the following?
Fibrinogen
Factor I

What factor is the following?
Prothrombin
Factor II

What factor is the following?
Tissue factor (or Tissue thromboplastin)
Factor III

What factor is the following?
Proaccelerin; labile factor
Factor V

What factor is the following?
Proconvertin, SPCA (serum prothrombin conversion accelerator)
Factor VII

What factor is the following?
Antihemophilic factor (AHF)
Factor VIII

What factor is the following?
Plasma thromboplastin component (PTC), Christmas factor
Factor IX

What factor is the following?
Stuart-Prower factor
Factor X

What factor is the following?
Plasma thromboplastin antecendent (PTA)
Factor XI

What factor is the following?
Hageman Factor
Factor XII

What factor is the following?
Fibrin stabilizing factor (FSF) prothrombin activator thrombokinase
Factor XIII

What factor is the following?
Calcium
Factor IV

all the factors are proteins except:
Factor IV (calcium) and PF3 (a phospholipid)

many of the steps in the cascades involve ____________ activation
zymogen

_________ is involved in many steps of the coagulation process as a cofactor
Ca2+

Extrinsic pathway begins with release of a ___________
tissue factor

what element is critical in both coagulation pathways?
Ca2+

Extrinsic pathway releases tissue factor which interacts with ________ to activate ________
Factor VII; Factor X

What forms prothrombin activator?
Factor Xa and factor V, Calcium, tissue/platelet phospholipids

both intrinsic and extrinsic pathways share the last ____ steps
four

Which pathway is the following:
1) Release of tissue factor: Traumatized tissue releases a complex of several factors called tissue factor or tissue thromboplastin
2) Activation of Factor X: Tissue factor further complexes with Factor VII and, in the presence of calcium ions, acts enzymatically on Factor X to form activated Factor X
- Factor Xa forms prothrombin activator— Factor Xa combines with tissue or platelet phospholipids as well as with Factor V to form the complex called prothrombin activator
Extrinsic pathway

Which pathway is the following:
1) Blood trauma causes a) activation of Factor XII and b) release of platelet phospholipids (containing platelet factor 3)
2) Activated Factor XII (XIIa) enzymatically activates Factor XI (XIa) which needs kininogen and is accelerated by prekallikrein
3) Factor XIa enzymatically activates Factor IX to IXa
4) Factor IXa + Factor VIIIa+ platelet phospholipids and factor 3 activates Factor X to Xa
5) Factor Xa+Factor V+ platelet or tissue phospholipid form the complex called prothrombin activator
6) The prothrombin activator in turn initiates within seconds the cleavage of prothrombin to form thrombin
Intrinsic pathway

The prothrombin activator intiaties the cleavage of
prothrombin to form thrombin

Which factor is a plasma protein produced in the liver and requires vitamin K?
Factor II (Prothrombin)

_____________ is a proteolytic enzyme that splits fibrinogen & Factor XIII into their activated forms Ia and XIIIa
thrombin

Prothrombin activator produced by the intrinsic or extrinsic pathways above PLUS __________, converts __________ to form __________
calcium, prothrombin (to form) thrombin

t/f: thrombin can also catalyze its own activation and can increase platelet aggregation
true

How does thrombin work?
thrombin splits two fibrinopeptides -> forms fibrin monomer -> monomers polymerize -> form protofibrils

Factor __________ catalyzes the formation of covalent bonds between the monomers and between adjacent fibrin chains to form branched fibers.
XIIIa (fibrin stabilizing factor)

A strong three-dimensional fibrous mesh surrounds the platelet plug to form a ____________
permanent clot

The cascade is an example of ____________. Each activated factor or complex catalyzes many reactions in the subsequent step.
Biological amplification

Protofibrils are held loosely together via
hydrogen and hydrophobic bonds

factors, once activated, adhere to the original site of injury and act ______
locally

Shortly after formation, the clot begins to shrink or retract. Most of the entrapped fluid (serum) oozes out of the clot. During retraction, the edges of small wounds are pulled together. Retraction results at least in part from the...
Contraction of platelet actomyosin

plasma with no clotting factors:
serum

when it is time to dissolve the clot, the clot itself induces release of _______________
plasminogen activator

What occurs gradually as new fibroblasts migrate to the injury site and begin the repair process?
dissolution of the clot (fibrinolysis)

Dissolution of the clot (fibrinolysis) requires the protein _______
plasmin

Normally blood flow is non-turbulent and flows over the negatively charged endothelial cell layer. Since most plasma proteins are themselves negatively charged, they are repelled from contact with ____________
Vessels walls

Where do anticoagulants circulate?
Plasma or on the endothelial surface

in healthy vessels, the epithelium and the plasma proteins are ______ charged and repel each other
negatively

prothrombin is a plasma protein produced in the:
liver

Prothrombin requires which vitamin?
vitamin K

thrombin is a proteolytic enzyme that splits ______ into its active form
fibrinogen

Define the following:
A polysaccharide produced by many cell types that interferes with activation of factor X
heparin

Define the following:
Inhibits activation of factor X via the extrinsic pathway
Tissue factor pathway inhibitor (TFPI)

Define the following:
Reacts with thrombin; resulting complex activates protein C & S which inhibit the action of factors VIIIa and Va
thrombomodulin

Define the following:
Protein that absorbs most of the thrombin that is formed, keeping it from spreading
fibrin

Define the following:
An a-globulin that binds excess thrombin
antithrombin II
